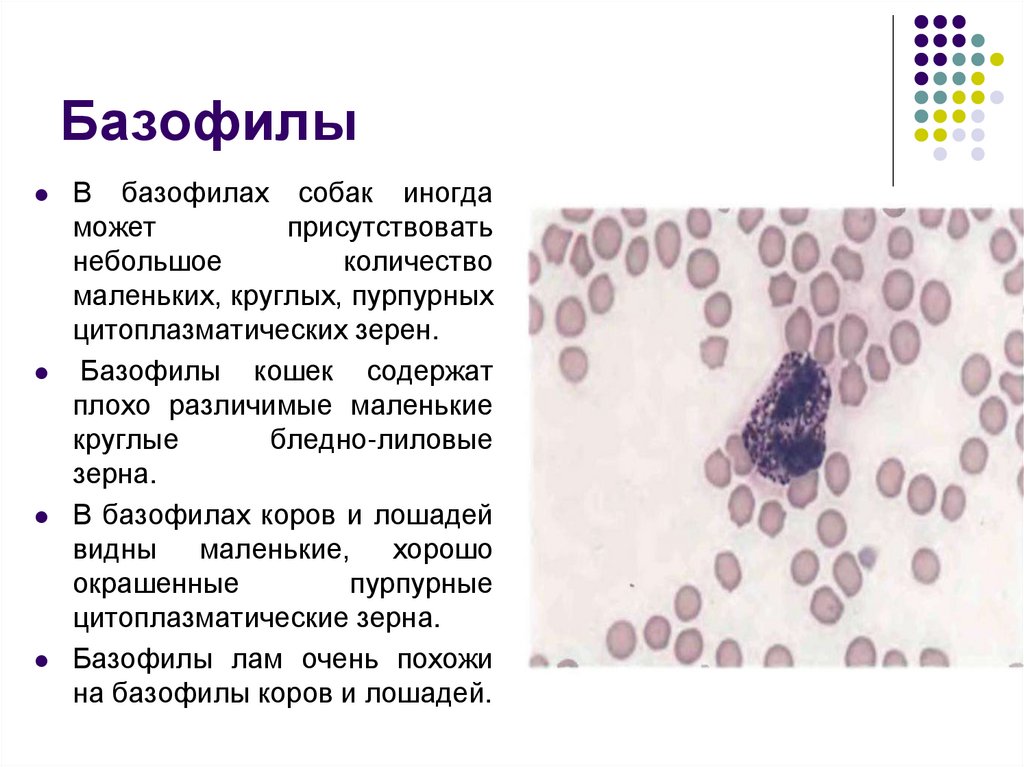
Базофилы

Похожие презентации:
Морфология нормальных эритроцитов
1. Морфология нормальных эритроцитов.
Зрелые эритроциты собак, кошек,лошадей и жвачных
Общие признаки
• не содержат ядра
• окрашиваются в
красноватый или
красноватооранжевый цвет
• имеют
форму
двояковогнутого
диска
Отличия
• размер
• интенсивность
центральной зоны
просветления
• слипание эритроцитов
в "монетный столбик"
• анизоцитоз.
2. Морфологические признаки нормальных эритроцитов
ВидДиаметр
(мкм)
Центральная
зона
просветления
"Монетный
столбик"
из эритроцитов
Анизоцитоз
Собака
7,0
++
+
—
Кошка
5,8
+
++
+
Лошадь
5,7
+/-
+++
-
Корова
5,5
+
-
+
Овца
4,5
+
+/-
+/-
Коза
3,2
+/-
+/-
+
Лама '
4,0 х 7,0*
-
-
+/-
3. Размеры
Эритроциты собак > кошек > лошадей >коров > овец > коз
Эритроциты собаки.
Эритроциты козы.
4. Интенсивность центральной зоны просветления
В эритроцитах собаки зона просветления выражена наиболееявно. В эритроцитах кошек, лошадей и жвачных эта зона выражена
менее ярко.
Эритроциты кошки
Эритроциты собаки.
Эритроциты овцы.
5. Слипание эритроцитов в "монетный столбик"
Слипание эритроцитов в"монетный столбик"
"Монетные столбики" из эритроцитов наиболее заметны в крови здоровых
лошадей, но также наблюдаются у кошек и значительно реже у собак. У лам
и коров не наблюдается ни в здоровом, ни в патологическом состоянии.
Мазок крови лошади
Эритроциты ламы. Эти клетки имеют
эллиптическую форму, центральная зона
просветления в них отсутствует.
6.
Feline blood flm with rouleaux(arrows) present, which appear as
stacked
erythrocytes (similar to a column of
coins); this amount of rouleaux is
normal in cats. Wright-Giemsa stain;
magnifcation, 200×.
Grapelike clusters of
agglutinated
RBCs (arrows) can be seen in
canine patients
with immune-mediated
hemolytic anemia.
Wright-Giemsa stain;
magnifcation, 200×.
7. Анизоцитоз
Анизоцитоз — это вариации в размереэритроцитов. Анизоцитоз в основном присутствует
в крови здоровых кошек и коров.
Эритроциты кошки. Эти эритроциты
меньше
эритроцитов
собаки,
наблюдается небольшая вариация в
размерах
(аниэоцитоз),
зона
просветления ограничена.
Эритроциты коровы. Наблюдается
небольшая вариация в размерах
(анизоцитоз), зона просветления
ограничена.
8. Ретикулоциты
в отдельной пробирке смешивается кровь с ЭДТА и растворбриллиантового крезилового синего в соотношении 1:1 или 1:4
У собак выделяют агрегатные ретикулоциты, а у кошек агрегатные и пунктатные
9. Морфология нормальных лейкоцитов.
Наиболеемногочисленными
клетками
в
периферической
кровеносной системе всех видов
домашних
животных,
за
исключением жвачных, являются
сегментоядерные
нейтрофилы.
Их диаметр колеблется от 10 до 12
мкм, у них одно ядро, состоящее из
нескольких долей. Обычно в ядре
насчитывается от 3 до 5 долей или
сегментов.
цитоплазма в нейтрофилах коров
окрашивается в ярко-розовый цвет
по сравнению с нейтрофилами
других видов животных. У лошадей
же сегменты выражены не так ярко.
10. Палочкоядерные нейтрофилы
Ядроу
палочкоядерных
нейтрофилов имеет форму
палочки.
Поскольку
палочкоядерные
нейтрофилы являются одной
из стадий дифференциации в
сегментоядерные
нейтрофилы, то возможны
отдельные выпуклости на
поверхности ядер.
11. Лимфоциты
Лимфоциты являются вторым почисленности клеточным типом в
циркулирующей
крови
большинства животных, и первым у
жвачных
имеют круглое, овальное или
слегка вытянутое ядро. Хроматин
состоит
из
гладких
зон
просветления, перемежающихся с
более
плотными
и
глыбообразными образованиями.
хроматин жвачных имеет более
ярко
выраженные
зоны
конденсации. Это может привести к
ошибочным выводам о присутствии
ядрышек в этих клетках.
12. Моноциты
В диаметре достигают 15—20мкм и имеют ядра различной
формы: овальные, овальные с
отдельными
выпуклостями
(бобовидные),
с
множественными выпуклостями
и дольчатостью.
Ядерный
хроматин
мелкозернистый или кружевной,
имеет
только
несколько
областей конденсации.
В небольшом количестве сероголубой цитоплазмы содержится
множество отдельных вакуолей
различного размера.
13. Эозинофилы
Зерна эозинофилов собак имеюткруглую форму и сильно варьируют
по размеру и количеству.
Зерна эозинофилов кошек имеют
палочковидную форму и заполняют
цитоплазму.
Эозинофилы
лошадей
имеют
большие, круглые, овальные или
продолговатые
зерна,
которые
заполняют цитоплазму и иногда
заслоняют ядро.
В
эозинофилах
жвачных
присутствуют маленькие круглые
одинаковые
зерна,
которые
заполняют цитоплазму.
У лам в эозинофилах находятся
маленькие круглые, овальные или
продолговатые зерна в малом
14. Базофилы
В базофилах собак иногдаможет
присутствовать
небольшое
количество
маленьких, круглых, пурпурных
цитоплазматических зерен.
Базофилы кошек содержат
плохо различимые маленькие
круглые
бледно-лиловые
зерна.
В базофилах коров и лошадей
видны маленькие, хорошо
окрашенные
пурпурные
цитоплазматические зерна.
Базофилы лам очень похожи
на базофилы коров и лошадей.

Медицина
Медицина Биология
Биология








